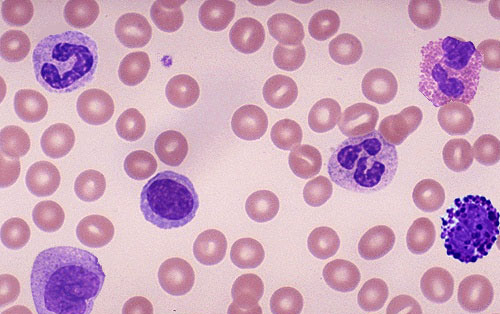

最近,第三军医大学新桥医院全军血液病中心发现一新的人类白细胞组织相容性抗原等位基因,相关论文已于近日发表在《Tissue antigens》杂志。据悉,这是重庆地区首个被世界卫生组织认证接受的人类白细胞等位基因。
第三军医大学新桥医院全军血液病中心发现一新的人类白细胞组织相容性抗原等位基因,相关论文已于近日发表在《Tissue antigens》杂志。据悉,这是重庆地区首个被世界卫生组织认证接受的人类白细胞等位基因。
目前对血液疾病最有效的治疗手段是造血干细胞移植,而移植所需的有血缘关系完全匹配的造血干细胞则越来越少,多数患者只能依靠中华骨髓库以及亲属间部分匹配的造血干细胞进行移植,而移植前的造血干细胞配型是治疗能否成功的关键要素。新桥医院全军血液病中心曾东风博士与其导师孔佩艳教授及西藏自治区总医院血液科魏立副教授等通力合作,历时3年完成了这一课题,其样本来源于一在西藏务工的重庆人。
据了解,该基因已被正式命名为HLA-C*01:73基因。这意味着在世界卫生组织人类HLA基因组库中,首次出现了代表重庆地区的HLA等位基因标志。曾东风博士介绍,造血干细胞移植治疗血液疾病,提供者和接受者HLA等位基因配型相吻合方可实施器官和骨髓移植,以保证移植的成功率以及术后排异反应低发生率。因此,新发现的HLA基因越多,造血干细胞移植配型的精确度就越高,移植成功率就越大。
新闻来源:http://www.huanqiukexue.com/html/newqqkj/newsm/2014/0623/24521.html

留言